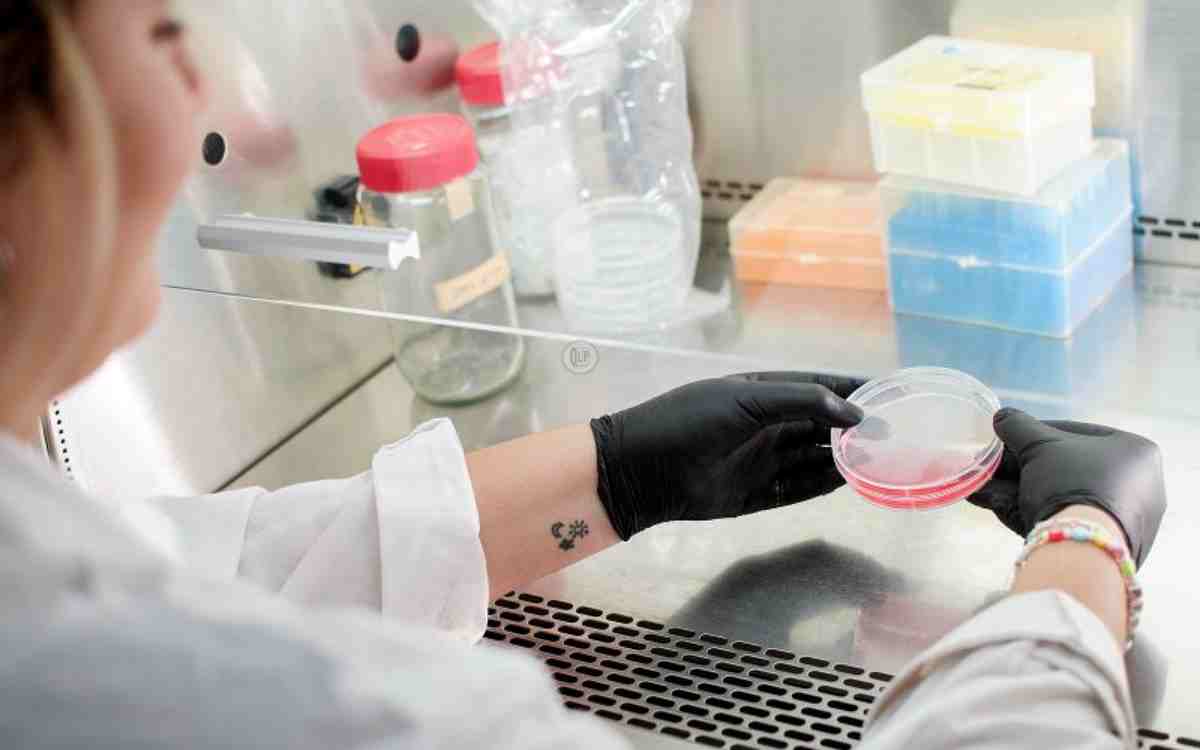

Investigadores de la Universidad Nacional de La Plata avanzan en el estudio de las enfermedades del sistema cardiovascular mediante técnicas moleculares que utilizan virus para el tratamiento de enfermedades genéticas. En esta oportunidad detectaron producción mayor a lo normal de una proteína particular, denominada IRBIT, en corazones de personas con miocardiopatía hipertrófica isquémica.
La investigación se lleva a cabo en el Centro de Investigaciones Cardiovasculares de la Facultad de Ciencias Médicas (CIC, UNLP-CONICET La Plata) que posee una amplia experiencia en el diseño, producción, control de calidad y utilización in vitro e in vivo de vectores virales adeno-asociados, un tipo de virus que se utiliza en las terapias génicas para corregir defectos en el genoma humano.

La miocardiopatía hipertrófica es un engrosamiento del músculo cardíaco, que dificulta su funcionamiento. Se trata de una enfermedad congénita o adquirida que se caracteriza por hipertrofia ventricular marcada y disfunción diastólica. Sus síntomas incluyen dificultad respiratoria, dolor torácico, síncope y muerte súbita.
Los virus adeno-asociados (AAV) constituyen un grupo de virus que requiere la coinfección con adenovirus u otros para replicarse. Está extendido en la población humana pero no está asociado con ninguna enfermedad conocida. Por tratarse de virus inofensivos, son ampliamente usados en la terapia génica. Pueden codificarse para funcionar como si fuesen interruptores, silenciando partes del genoma que producen -expresan, en lenguaje genético- las proteínas.

Con estas herramientas, los investigadores del CIC pudieron asociar el exceso de la proteína IRBIT a la miocardiopatía isquémica.
Alejandro Orlowski, uno de los responsables del proyecto, explicó que en un trabajo realizado por Romina Di Mattia, becaria postdoctoral de la Facultad, “hemos descripto que la proteína IRBIT se encuentra sobreexpresada tanto en corazones de pacientes con miocardiopatía isquémica como en un modelo animal de cardiopatía hipertrófica. Este fenotipo patológico puede ser desencadenado cuando se aumenta a través de la ingeniería genética la cantidad de proteína, es decir se sobreexpresa a través de un vector viral adeno-asociado”.

Un paso más para revertir la patología
La disminución de la producción de la proteína mediante su silenciamiento a través de un vector adeno-asociado revertiría la patología, sugiriendo un posible blanco terapéutico. Este proceso se realiza a través de un ARN de interferencia específico codificado en un vector adeno-asociado.
IRBIT es una proteína multifuncional, identificada por científicos japoneses a principios de los 2000, que desempeña papeles importantes en la regulación del calcio intracelular, el metabolismo y el equilibrio celular. Si bien se presume que puede estar relacionada con algunas patologías, cabe destacar que se trata del primer aporte que hace la ciencia sobre el posible rol de la proteína IRBIT en la fisiopatología cardíaca.
La historia de los tratamientos más caros del mundo
En 1965 el laboratorio de William Hammond en la Universidad de Pittsburg de Estados Unidos describió por primera vez que las partículas contaminantes halladas en los cultivos de adenovirus eran en realidad pequeños virus defectuosos en su replicación. Los denominaron virus adeno-asociados ya que su amplificación sólo era exitosa con la infección simultánea de un adenovirus.
Los adeno-asociados son virus pequeños, de 25 nm, sin envoltura y con un genoma de simple hebra de ADN que codifica para las proteínas de la replicación y para las proteínas de la cápside. Estos virus son excelentes candidatos para ser utilizados como vectores virales en terapia génica in vivo debido principalmente a su seguridad (no se encuentran asociados a ninguna patología conocida en humanos), a su gran resistencia a la degradación (facilitando su producción, almacenamiento y traslado), a su capacidad de expresión estable del transgen y a su baja inmunogenicidad.
Otra importante característica de los adeno-asociados es su capacidad de infectar diferentes tipos celulares según el serotipo.

El primer tratamiento aprobado para utilizar AAV como vector para terapia génica fue desarrollado por Glybera en el 2012 para tratar la deficiencia en lipoproteína lipasa. A pesar de que el tratamiento fue discontinuado años posteriores por su alto costo y la existencia de tratamientos alternativos más económicos, la aprobación de esta droga marcó un hito en el desarrollo de terapias génicas utilizando vectores virales. En el 2017 se lanzó al mercado Luxturna para el tratamiento de pacientes con distrofia retiniana que provoca la pérdida de la visión causando ceguera y la siguió en el 2019 Zolgensma para el tratamiento de la Atrofia Muscular Espinal (AME). Esta última es conocida en nuestro país debido a que esta enfermedad tiene una mortalidad muy alta en los primeros años de vida y ha habido reiteradas campañas de donaciones para lograr pagar el alto costo en dólares que posee el tratamiento (2,1 millones de dólares la dosis). Recientemente, el Estado argentino provee este tratamiento para quien lo requiera con un costo anual de 15 millones de dólares anuales.

En los últimos años nuevos tratamientos fueron aprobados por la EMA y la FDA, entre ellos se destaca Hemgenix para el tratamiento de la hemofilia B, con un valor de 3,5 millones de dólares la dosis, siendo actualmente, la droga más costosa que existe en el mundo.
Tecnología de vanguardia
La tendencia mundial es que prontamente aparezcan nuevos tratamientos basados en vectores AAV para la transferencia génica desplazando a los demás vectores virales. La revolución de su uso como vector para el tratamiento de enfermedades genera que en el mundo cada vez más empresas invierten en esta tecnología con el objetivo de aumentar la producción de estos vectores, intentando satisfacer las necesidades globales y con una marcada tendencia en aumento para los próximos años. La utilización de estos vectores en los laboratorios de investigación crece exponencialmente siendo una herramienta importante para el desarrollo de la ciencia fundamental como la aplicación de la misma.

Hasta el momento, en Argentina no existen servicios en organismos de investigación que posean la capacidad de producir vectores AAV a una escala suficiente para su comercialización. Tampoco existen proveedores en Latinoamérica, de modo que la única opción local es pagar altos costos en dólares a empresas extranjeras, con tiempos de entrega largos y sin un servicio de consulta y asesoramiento cercano. Este atraso técnico/metodológico en Latinoamérica provoca una dependencia científica con los países líderes en terapia génica como es el caso de Estados Unidos, China, Unión Europea y Reino Unido.

En este contexto, las investigaciones realizadas en el Centro de Investigaciones Cardiovasculares y sus amplias capacidades con la producción y uso de vectores virales adeno-asociados posicionan a la UNLP en una línea de vanguardia y con mucho potencial para la industria farmacéutica.